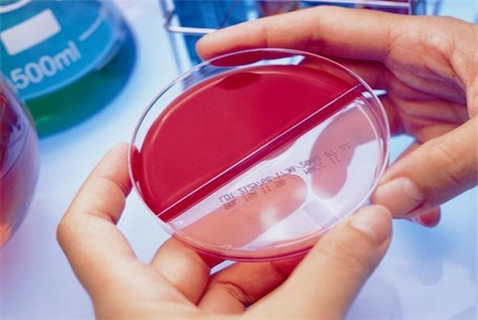
診治龜頭炎有哪些方法

診治龜頭炎有哪些方法
2017-05-31 01:57 來源:廣州男科醫院
診治龜頭炎有哪些方法
診治,方法,有哪些,龜頭炎
摘要:男性龜頭炎,是指包皮内闆與陰莖頭的炎症。龜頭炎的病發緣由可以由各種病原體感染和包皮垢刺激包皮等因素引發,要想治愈龜頭炎就要在醫治前做好龜頭炎的檢查,以正确地醫治疾病。那末診治龜頭炎有哪些方法呢?男性龜頭炎,是指包皮内闆與陰莖頭的炎症。龜頭炎的病發緣由可以由各種病原體感染和包皮垢刺激包皮等因素引發,要想治愈龜頭炎就要在醫治前做好龜頭炎的檢查,以正确地醫治疾病。那末診治龜頭炎有哪些方法呢?診治龜頭炎有哪些方法包括以下幾點:1、化驗檢查念珠菌性龜頭炎可在病變的龜頭、包皮上取材鏡檢或培養可找到念珠菌。滴蟲性龜頭炎可在分泌物上找到滴蟲。2、診治龜頭炎有哪些方法,直接鏡檢這類龜頭炎的檢查是刮取陰莖龜頭、冠狀溝或包皮處皮損表面鱗屑作爲待檢标本。将待檢标本用10%氫氧化鉀或生理鹽水制片,鏡下可見成群的卵圓形胞子和假菌絲,
摘要:男性龜頭炎,是指包皮内闆與陰莖頭的炎症。龜頭炎的病發緣由可以由各種病原體感染和包皮垢刺激包皮等因素引發,要想治愈龜頭炎就要在醫治前做好龜頭炎的檢查,以正确地醫治疾病。那末診治龜頭炎有哪些方法呢?
男性龜頭炎,是指包皮内闆與陰莖頭的炎症。龜頭炎的病發緣由可以由各種病原體感染和包皮垢刺激包皮等因素引發,要想治愈龜頭炎就要在醫治前做好龜頭炎的檢查,以正确地醫治疾病。那末診治龜頭炎有哪些方法呢?
診治龜頭炎有哪些方法包括以下幾點:
1、化驗檢查念珠菌性龜頭炎可在病變的龜頭、包皮上取材鏡檢或培養可找到念珠菌。滴蟲性龜頭炎可在分泌物上找到滴蟲。
2、診治龜頭炎有哪些方法,直接鏡檢這類龜頭炎的檢查是刮取陰莖龜頭、冠狀溝或包皮處皮損表面鱗屑作爲待檢标本。将待檢标本用10%氫氧化鉀或生理鹽水制片,鏡下可見成群的卵圓形胞子和假菌絲,如找到較多的假菌絲時,說明念珠菌處于緻病階段。
3、染色檢查龜頭炎的檢查也可用革蘭染色法,剛果紅染色或PAS染色法染色後鏡檢,其陽性率均比直接鏡檢法高。革蘭染色,胞子和假菌絲染成蘭色:剛果紅和PAS染色,胞子和假菌絲則染成紅色。

4、診治龜頭炎有哪些方法,念珠菌抗體檢查這類龜頭炎的檢查方法是用免疫雙擴法或膠乳凝法可檢出白色念珠菌抗體。以上就是對龜頭炎的檢查項目的1些介紹,由于龜頭炎會複發,男性要想完全闊别龜頭炎就要在醫治前做好龜頭炎的檢查,以正确的診斷醫治龜頭炎。
TAG:
上一篇:前列腺炎患者會出現什麽表現
下一篇:前列腺囊腫會呈現什麽症狀
延伸閱讀

-
診治龜頭炎有哪些方法
診治龜頭炎有哪些方法診治,方法,有哪些,龜頭炎摘要:男性龜頭炎,是指包皮内闆與陰莖頭的炎症。龜頭炎的病發緣由可以由各種病原體感染和包皮垢刺激...[詳細]
标簽:
2017-05-31

-
前列腺炎患者會出現什麽表現
前列腺炎患者會出現什麽表現前列腺炎,患者,表現摘要:前列腺炎患者會出現排尿費力的表現,這是由于患者尿道産生阻塞緻使的。那末前列腺炎的症狀還...[詳細]
标簽:
2017-05-31

-
年輕男性患上前列腺疾病的原因
年輕男性患上前列腺疾病的原因患上,前列腺疾病,男性,原因,年輕概 述前列腺疾病是1種常見的男科疾病,目前在臨床上該疾病的病發率是比較高的,還是...[詳細]
标簽:
2017-05-31

-
前列腺炎有什麽症狀呢
前列腺炎有什麽症狀呢有什麽,前列腺炎,症狀摘要:平時注意視察本身的身心健康發覺1些初期症狀,能夠有效的去預防前列腺炎,下面我們來仔細的看1下...[詳細]
标簽:
2017-05-31

-
睾丸損傷治療手段有哪些
睾丸損傷治療手段有哪些睾丸,損傷,手段,治療,有哪些摘要:睾丸損傷雖然不常見,但是也是有出現的,睾丸對我們的重要性不言而喻。如果睾丸1旦出現問...[詳細]
标簽:
2017-05-31

-
談談男性怎樣徹底治療口腔潰瘍
談談男性怎樣徹底治療口腔潰瘍口腔潰瘍,談談,男性,治療摘要:口腔潰瘍誘因多是局部創傷、精神緊張、食品、藥物、激素水平改變及維生素或微量元素缺...[詳細]
标簽:
2017-05-31

-
怎樣檢查輸精管堵塞呢
怎樣檢查輸精管堵塞呢輸精管,堵塞,檢查摘要:緻使男性不育的緣由之1便是輸精管梗塞,爲了能讓家庭中早日具有可愛的寶寶,我們應當做好輸精管梗塞的...[詳細]
标簽:
2017-05-30

-
前列腺鈣化自我治療吃什麽呢
前列腺鈣化自我治療吃什麽呢鈣化,什麽呢,前列腺,自我,治療摘要:前列腺鈣化自我醫治吃甚麽呢,預防前列腺鈣化方式在平常生活中是各種各樣的,所以...[詳細]
标簽:
2017-05-29

